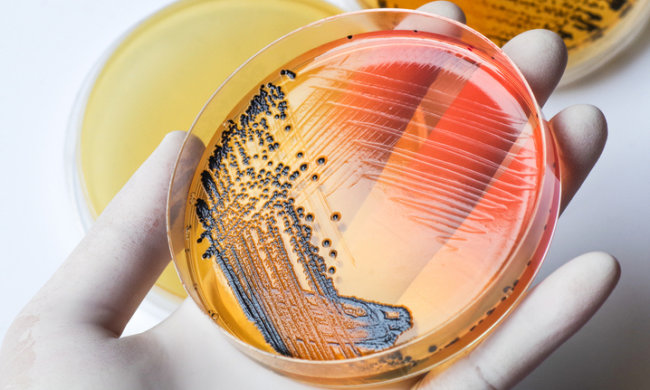
"Клітини-домосіди" допоможуть боротися з небезпечною інфекцією

Здоров'я, сторінка 220
"Клітини-домосіди" допоможуть боротися з небезпечною інфекцією
Вакцина вже в розробці

Виявлено "фотографуючу" область мозку
Чому у нас не темніє в очах, коли ми моргаємо

Хвороба велетнів: вчені виявили нову причину варикозу
Нове дослідження пролило світло на хворобу ніг

Вчені знайшли "винуватця" всіх депресій
Нове дослідження підтвердило припущення вчених

Що означає білий наліт на язику
Коли слід звертатися до лікаря

Отримай відповідь: що таке хлорний висип і як його лікувати
Методи профілактики шкірного захворювання

Перевірено вченими: наскільки ефективні засоби від похмілля
Медики перевірили 5 популярних засобів

Топ-5 продуктів, які містять омега-3
Заповнюємо дефіцит жирних кислот в організмі

Дихніть в трубочку: вчені винайшли експрес-тест на втому
Новий винахід допоможе скоротити кількість аварій

Потрібно знати кожній мамі: 5 міфів про дитяче здоров'я, які давно пора розвінчати
У ці міфи потрібно перестати вірити якомога швидше

Як таке можливо: величезна черепаха окупувала причандали британки, слабкодухим не дивитися
26-річна британка звернулася в лікарню зі скаргами на болі

Улюблена дієта знаменитостей виявилася смертельно небезпечною
Лікарі попередили про величезну шкоду такого раціону

Як визначити рак печінки: перші симптоми, лікування і профілактика
Найкраща профілактика – це турбота про своє здоров'я

Медики розповіли про головну небезпеку неправильного сну
Призводить до розвитку серйозних захворювань

Бургери, кава і вечірні "зажори": 10 цікавих фактів про харчування Аніти Луценко
Що в тарілці у найвідомішого тренера країни

Медики навчилися лікувати запор електрикою
Новий метод вже успішно протестований

Менше за монетку: медики винайшли гаджет проти безпліддя
Новий винахід допоможе мільйонам безплідних пар

Жителі Землі вимирають рекордними темпами, і справа не в хворобах
Кожна двадцята смерть пов'язана з вживанням алкогольних напоїв.

Найгірше жінкам: що з робить організмом відсутність інтиму
Винятком може бути тільки відмова від інтимної близькості, якщо є рекомендації лікаря

Пружні сідниці і підтягнуті ноги: комплекс вправ від Аніти Луценко
Аніта опублікувала відео, представивши кілька вправ, які допоможуть підкачати м'язи сідниць і ніг
Вибір редакції







29 квітня – день дев'яти цілителів: що потрібно обов'язково попросити, щоб не хворіти весь рік, прикмети та заборони

Жарт, що може коштувати кар’єри: Блейк Лайвлі готує удар по Бальдоні через історію з Брітні Спірс

Чому не можна стригти нігті 28 квітня і чому сьогодні потрібно бути ситим: прикмети та заборони на Максима

Не ламайте бузок – пошкодуєте: правда, яка зіпсує вам весняні букети

Повалій після втрати майна в Україні заявила, що її "врятували" і вивезли до рф: скандальні слова з Криму

Що не можна викидати 27 квітня і навіщо кликати гостей сьогодні: прикмети та заборони на Стефана

У росії під наглядом пожежників випадково спалили півсела

Віра Брежнєва ледь прикрила форми на сцені зухвалим вбранням: "Готова схуднути"

Дзідзьо зізнався, що подарував Slavia після розлучення: "Ти виходиш - і вид на озеро"

Леся Нікітюк в прозорій блузочці заговорила про багатих чоловіків: "Спасибі, я сама"

Наталя Могилевська скинула 7 зайвих кіло і показала результат у сміливій сукні: "Заслужила"

Російська Кардашьян Анастасія Квітко перетворилася на Рапунцель з неосяжними сідницями

Фітнес-модель Ана Чері в зухвалому бікіні пограла у воді: справжня тигриця

Модель плюс-сайз Джоджо Бейбі оголила груди просто на пробіжці: розстебнулася блискавка










